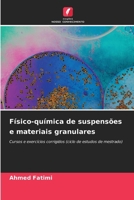
Físico-química de suspensões e materiais granulares 6207282299 Book Cover
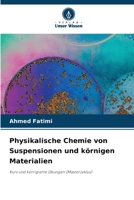
Physikalische Chemie von Suspensionen und körnigen Materialien 6207282116 Book Cover
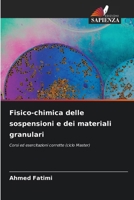
Fisico-chimica delle sospensioni e dei materiali granulari 6207282280 Book Cover

Étude Des Propriétés Rhéologiques Des Hydrogels Biomédicaux
Out of Stock

Stabilité Et Propriétés Rhéologiques Des Suspensions
Out of Stock

Physico-chemistry of suspensions and granular materials
Out of Stock
Físico-química de suspensões e materiais granulares
Out of Stock
Physikalische Chemie von Suspensionen und körnigen Materialien
Out of Stock
Fisico-chimica delle sospensioni e dei materiali granulari
Out of Stock